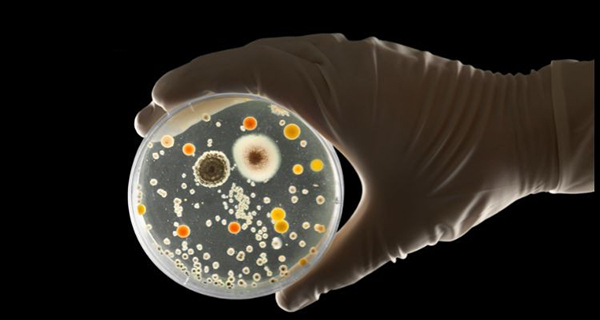
Hình ảnh minh họa khuẩn lạc trong vi sinh học
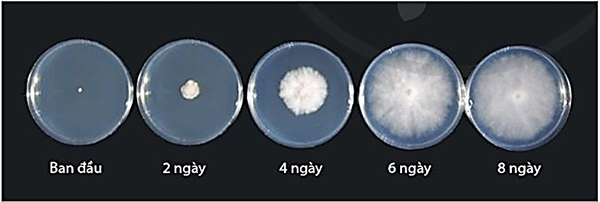
Hình ảnh quá trình hình thành và phát triển khuẩn lạc theo từng ngày trên đĩa nuôi cấy
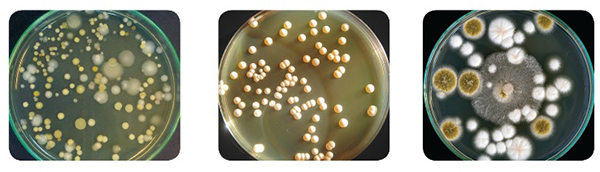
So sánh hình thái khuẩn lạc theo vi sinh vật bao gồm vi khuẩn, nấm men và nấm mốc
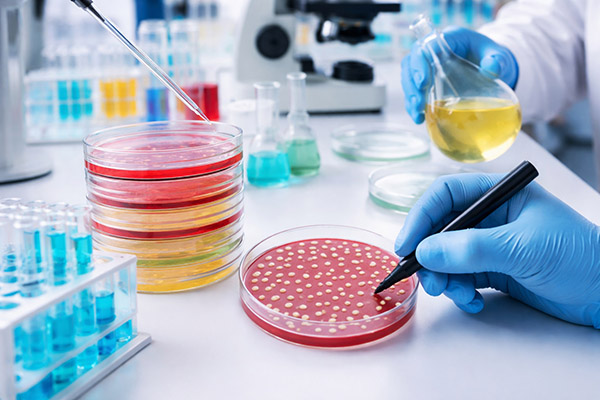
Vai trò quan trọng của khuẩn lạc trong đời sống hàng ngày

Khuẩn lạc là cấu trúc được hình thành dựa trên sự phát triển của vi sinh vật trên các môi trường nuôi cấy rắn. Đây là đơn vị cơ bản nhưng cực kỳ quan trọng giúp các nhà khoa học, kỹ thuật viên phân tích, định danh và định lượng vi khuẩn trong nghiên cứu cũng như kiểm nghiệm. Bài viết này, MT giúp bạn hiểu rõ khuẩn lạc là gì, các loại khuẩn lạc và những phương pháp đếm khuẩn lạc phổ biến hiện nay.

Khuẩn lạc là gì?
Trong lĩnh vực vi sinh vật học, khuẩn lạc (Colony) được định nghĩa là một nhóm các tế bào vi sinh vật có thể nhìn thấy bằng mắt thường, phát triển trên bề mặt của môi trường nuôi cấy dạng rắn (thường là đĩa thạch).
Về mặt lý thuyết, một khuẩn lạc được hình thành từ sự sinh sôi nảy nở của một tế bào mẹ ban đầu. Tuy nhiên, nó cũng có thể phát triển từ một nhóm tế bào hoặc một đoạn bào tử. Chính vì vậy, trong các phép đo định lượng, chúng ta thường sử dụng đơn vị CFU thay vì đếm số lượng tế bào tuyệt đối.
Quá trình hình thành khuẩn lạc
Sự hình thành khuẩn lạc không diễn ra ngay lập tức mà là kết quả của một quá trình sinh trưởng theo cấp số nhân. Quy trình này thường diễn ra theo các bước sau:
- Cấy mẫu: Mẫu chứa vi sinh vật được cấy trải hoặc cấy ria lên bề mặt đĩa thạch dinh dưỡng.
- Giai đoạn tiềm phát (Lag phase): Tế bào thích nghi với môi trường mới, chưa phân chia nhưng tổng hợp các enzyme cần thiết.
- Giai đoạn tăng trưởng (Log phase): Tế bào bắt đầu phân chia mạnh mẽ (thường là phân đôi). Từ một tế bào ban đầu, sau hàng triệu lần phân chia, chúng tạo thành một khối tế bào đủ lớn.
- Hình thành Colony: Khối tế bào này trở nên hữu hình, tạo thành các đốm màu trên bề mặt thạch với hình dạng đặc trưng.
Các yếu tố như nhiệt độ ủ, thời gian, độ pH và thành phần dinh dưỡng của môi trường nuôi cấy sẽ ảnh hưởng trực tiếp đến kích thước và tốc độ hình thành của khuẩn lạc.
Các hình thái của một số khuẩn lạc
Việc quan sát hình thái khuẩn lạc là bước đầu tiên trong việc định danh sơ bộ vi sinh vật. Các đặc điểm này rất đa dạng và phụ thuộc vào từng loài:
- Hình dạng (Form): Có thể là hình tròn, hình thoi, hình không đều hoặc dạng sợi.
- Độ nổi (Elevation): Khuẩn lạc có thể dẹt), lồi, lồi nệm hoặc hình rốn.
- Mép (Margin): Mép nguyên, răng cưa hoặc lượn sóng.
- Kích thước: Dao động từ rất nhỏ (dạng sương mù) đến lớn vài mm hoặc cm.
- Màu sắc: Đây là đặc điểm quan trọng. Ví dụ: Staphylococcus aureus thường có màu vàng, Pseudomonas aeruginosa có thể sinh sắc tố xanh.
- Bề mặt & Độ trong: Bề mặt có thể trơn nhẵn, sần sùi hoặc nhầy ướt. Độ trong có thể là trong suốt, đục hoặc mờ.
Lưu ý: Các đặc điểm này được mô tả chi tiết giúp phân biệt các nhóm vi khuẩn khác nhau trên cùng một đĩa nuôi cấy.

Phân loại khuẩn lạc
Dựa vào nguồn gốc vi sinh vật và đặc điểm cấu trúc bề mặt, khuẩn lạc có thể được phân loại như sau:
Phân loại theo vi sinh vật
- Khuẩn lạc vi khuẩn: Thường nhỏ, bề mặt ướt, bóng hoặc nhầy, mép đều. Màu sắc đa dạng tùy loài.
- Khuẩn lạc nấm men: Thường có dạng tròn, lồi, màu trắng đục hoặc màu kem, có mùi thơm đặc trưng (giống rượu hoặc bánh mì).
- Khuẩn lạc nấm mốc: Thường lớn, lan rộng, có dạng sợi bông hoặc bột phấn do sự phát triển của hệ sợi nấm và bào tử. Màu sắc thường sẫm hoặc có các vòng đồng tâm.
Phân loại theo hình thái (Dạng S, R, M)
Trong vi sinh lâm sàng, người ta còn phân loại dựa trên tính chất bề mặt:
- Dạng S (Smooth – Trơn): Khuẩn lạc tròn, lồi, bóng, mép đều. Thường gặp ở các vi khuẩn có độc lực cao, vỏ polysaccharide nguyên vẹn.
- Dạng R (Rough – Nhám): Khuẩn lạc dẹt, bề mặt khô, nhăn nheo, mép răng cưa. Thường là dạng ít độc lực hoặc không có vỏ.
- Dạng M (Mucoid – Nhầy): Khuẩn lạc nhầy, dính, thường gặp ở các vi khuẩn có lớp vỏ capsule dày (ví dụ: Klebsiella pneumoniae).
Ứng dụng của khuẩn lạc trong đời sống
Hiểu về khuẩn lạc nấm men là gì và đặc tính của chúng mang lại giá trị to lớn trong nhiều lĩnh vực:
- Y học & Chẩn đoán: Nuôi cấy bệnh phẩm (máu, nước tiểu…) để tìm khuẩn lạc vi khuẩn gây bệnh. Từ đó thực hiện kháng sinh đồ để tìm ra phác đồ điều trị hiệu quả.
- Kiểm nghiệm an toàn thực phẩm: Đếm khuẩn lạc trên đĩa Petri để xác định tổng số vi khuẩn hiếu khí, Coliforms, E.coli… nhằm đánh giá mức độ vệ sinh và an toàn của thực phẩm theo quy chuẩn (ví dụ TCVN).
- Nghiên cứu khoa học: Phân lập các chủng vi sinh vật mới, nghiên cứu khả năng sinh enzyme, kháng sinh hoặc các hoạt chất sinh học từ khuẩn lạc đơn lẻ.
Các phương pháp đếm khuẩn lạc phổ biến
Để định lượng vi sinh vật, các nhà nghiên cứu sử dụng hai chỉ số chính là CFU và MPN. Dưới đây là các phương pháp chi tiết:
Phương pháp đếm khuẩn lạc thủ công (Standard Plate Count)
Đây là phương pháp truyền thống và phổ biến nhất để xác định chỉ số CFU.
- Quy trình: Mẫu được pha loãng theo bậc thập phân, sau đó cấy vào đĩa thạch. Sau khi ủ, kỹ thuật viên sẽ đếm khuẩn lạc trên đĩa Petri bằng mắt thường hoặc kính lúp.
- Ưu điểm: Chi phí thấp, quan sát được hình thái khuẩn lạc.
- Nguyên tắc: Chỉ đếm các đĩa có số lượng khuẩn lạc nằm trong khoảng 25-250 hoặc 30-300 khuẩn lạc.
Chỉ số MPN (Most Probable Number)
Khác với CFU đếm trực tiếp trên môi trường rắn, MPN là phương pháp thống kê xác suất dựa trên nuôi cấy trong môi trường lỏng. Thường dùng cho các mẫu có mật độ vi sinh vật thấp hoặc nền mẫu phức tạp (như bùn, đất).
Phương pháp đếm khuẩn lạc tự động
Sử dụng các máy đếm khuẩn lạc chuyên dụng. Máy sử dụng camera và phần mềm xử lý hình ảnh để nhận diện và đếm số lượng khuẩn lạc chỉ trong vài giây.
Phương pháp này mang lại nhiều ưu điểm nổi bật như: Nhanh chóng, chuẩn hóa dữ liệu, giảm sai sót do con người, lưu trữ hình ảnh minh chứng.

Địa chỉ mua máy móc thiết bị lên men khuẩn lạc nấm men uy tín
Việc nuôi cấy và phân tích khuẩn lạc, đặc biệt là trong quy trình lên men công nghiệp (như sản xuất bia, vaccine, chế phẩm sinh học từ nấm men), đòi hỏi hệ thống thiết bị đồng bộ và đạt tiêu chuẩn chất lượng cao. Hệ thống thiết bị từ các nồi lên men (bioreactors/fermenters) giúp kiểm soát quá trình sinh khối đến các công đoạn lọc và xử lý hạ nguồn, đều cần được đầu tư một cách đồng bộ.
Nếu bạn đang tìm kiếm giải pháp toàn diện cho phòng thí nghiệm hoặc nhà máy sản xuất của mình, MT là đối tác đáng tin cậy hàng đầu. Lý do nên chọn MT:
- Chuyên gia trong lĩnh vực: MT chuyên cung cấp các giải pháp quy trình công nghệ sinh học, từ thiết kế, phát triển đến lắp đặt hệ thống lên men vi sinh và nuôi cấy tế bào.
- Sản phẩm đa dạng: Cung cấp đầy đủ các thiết bị như Bioreactors, Fermenters, hệ thống lọc dòng chảy chéo (TFF), hệ thống CIP/SIP và các dòng máy đếm khuẩn lạc tiên tiến.
- Dịch vụ tận tâm: Với sứ mệnh “Trở thành một phần thành công của bạn”, MT mang đến dịch vụ hậu mãi, bảo trì và tư vấn kỹ thuật tốt nhất, giúp tối ưu hóa hiệu suất nghiên cứu và sản xuất của khách hàng.
Để được tư vấn chi tiết về các thiết bị lên men và giải pháp phòng thí nghiệm, hãy truy cập ngay website chính thức của MT.

Qua bài viết, có thể thấy khuẩn lạc không chỉ là dấu hiệu trực quan của vi sinh vật mà còn là cơ sở quan trọng để nhận diện, định lượng và đánh giá mức độ nhiễm khuẩn. Để quá trình nuôi cấy và quan sát đạt độ chính xác cao, việc đầu tư thiết bị phù hợp là yếu tố then chốt. Nếu bạn đang tìm giải pháp chuyên nghiệp, MT là địa chỉ uy tín cung cấp máy móc lên men, nuôi cấy khuẩn lạc chất lượng, đáp ứng tiêu chuẩn phòng thí nghiệm. Liên hệ ngay hotline: 0767 067 567 để được hỗ trợ!
